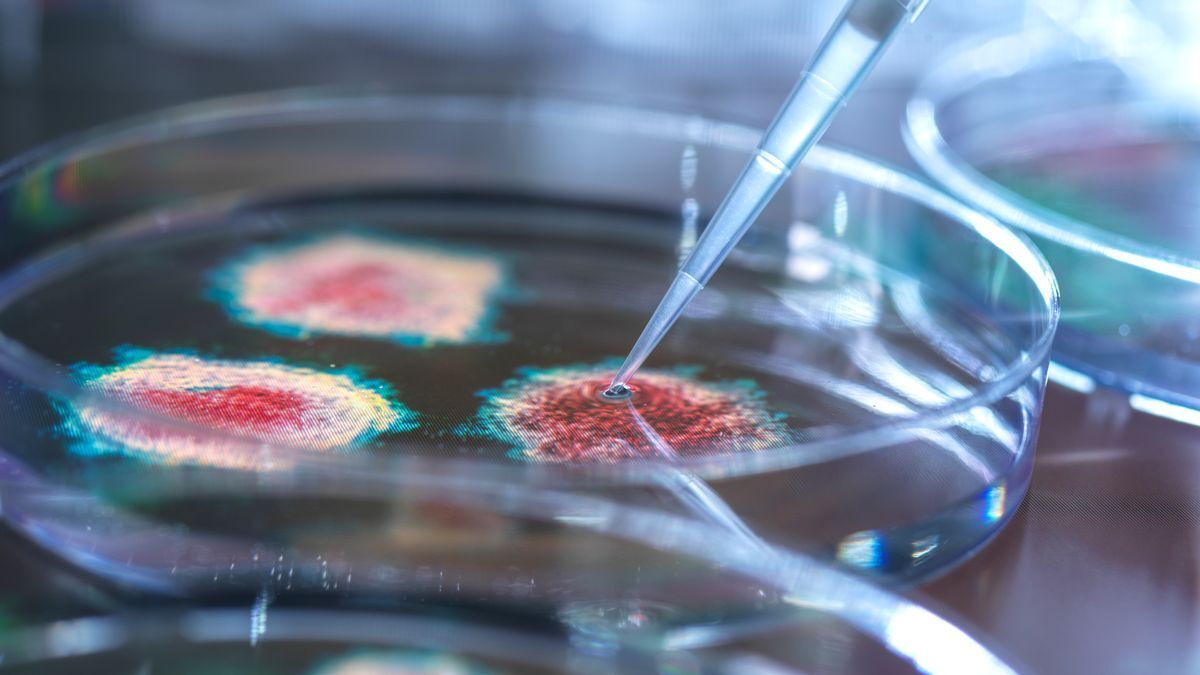
Вирус Covid может повысить риск заражения другими серьёзными заболеваниями

Вирус Covid может повысить риск заражения другими серьёзными заболеваниями
Исследователи выступили с предупреждением после нового исследования влияния вируса на бактерии в организме
Вирус нарушает нормальный баланс кишечных бактерий, как выяснили учёные, поскольку менее разнообразная микрофлора кишечника означает, что опасным микробам легче процветать.
Люди, перенёсшие Ковид, могут быть более уязвимы к другим инфекциям из-за изменений, которые вирус производит в кишечнике пациентов.
Вирус нарушает нормальный состав кишечных бактерий, уменьшая количество различных видов, утверждают учёные. Менее разнообразная микрофлора кишечника означает, что опасным микробам легче процветать.
Пациенты также могут подвергаться большему риску опасных для жизни вторичных инфекций, поскольку устойчивые к антибиотикам виды могут попасть в кровь, показало исследование.
Соавтор исследования профессор Кен Кадвелл из Нью-Йоркского университета Лангоне (США) сказал: "Наши результаты показывают, что коронавирусная инфекция напрямую нарушает здоровый баланс микробов в кишечнике, подвергая пациентов дальнейшей опасности.
"Теперь, когда мы раскрыли источник этого бактериального дисбаланса, врачи смогут лучше определять пациентов с коронавирусной инфекцией, наиболее подверженных риску вторичной инфекции кровотока".

В кишечнике человека обычно обитает целая экосистема бактерий, которые работают вместе, чтобы поддерживать ваше здоровье, но "Ковид" может нарушить этот баланс.
Исследование, опубликованное в журнале Nature Communications, основывается на результатах предыдущих исследований, которые показывают, что широкое использование антибиотиков привело к повышению устойчивости бактерий, что делает людей более уязвимыми к инфекциям.
Профессор Кэдвелл сказал: "Новое исследование впервые показывает, что сама по себе коронавирусная инфекция, а не первоначальное применение антибиотиков для лечения болезни, как считали другие эксперты, повреждает микробиом кишечника.
"Исследование также предоставляет первые доказательства того, что те же самые бактерии в кишечнике попадают в кровь пациентов, вызывая опасные инфекции".
Команда исследовала 96 мужчин и женщин, которые были госпитализированы с Covid-19 в 2020 году в Нью-Йорке и Нью-Хейвене в США.

Исследователи взяли образцы у людей, заражённых вирусом, чтобы изучить, что произошло с их кишечными бактериями
Они обнаружили, что у большинства пациентов было очень низкое разнообразие микробиома кишечника, причём у 25 процентов из них в кишечнике был только один вид бактерий.
Они также обнаружили, что количество видов бактерий, устойчивых к антибиотикам, увеличилось, что может быть связано с более активным использованием антибиотиков на ранних стадиях пандемии.
Более того, у 20 процентов пациентов эти устойчивые к антибиотикам бактерии, обнаруженные в кишечнике, мигрировали в кровь, что повышало риск развития опасных инфекций.
Чтобы сделать выводы, исследователи заразили десятки мышей вирусом Covid-19 и проанализировали виды бактерий в образцах кала. Этот шаг позволил им выяснить, может ли один лишь Covid-19 непосредственно нарушить микробиом кишечника.

Учёные обнаружили, что некоторые устойчивые к антибиотикам бактерии выходили из кишечника в кровь пациентов
Затем они взяли образцы кала и крови у пациентов с Covid-19 в больницах New York University Langone Health и Yale University. Они проанализировали бактерии в кишечнике и искали вторичные инфекции.
Старший автор исследования доктор Йонас Шлютер, доцент кафедры микробиологии Нью-Йоркского университета Лангоне, сказал: "Наши результаты показывают, что микробиом кишечника и различные части иммунной системы организма тесно взаимосвязаны.
"Инфекция в одной из них может привести к серьезным нарушениям в другой".
Однако д-р Шлютер предупредил, что необходимо провести дополнительные исследования. Он добавил: "Поскольку пациенты получали различные виды лечения своих заболеваний, исследование не смогло полностью учесть все факторы, которые могли способствовать нарушению их микробиома и ухудшению их заболевания".
Далее команда планирует изучить, почему определенные виды микробов с большей вероятностью покидают кишечник во время Covid-19, и они намерены исследовать, как взаимодействуют различные микробы, которые могут способствовать этой миграции в кровоток.